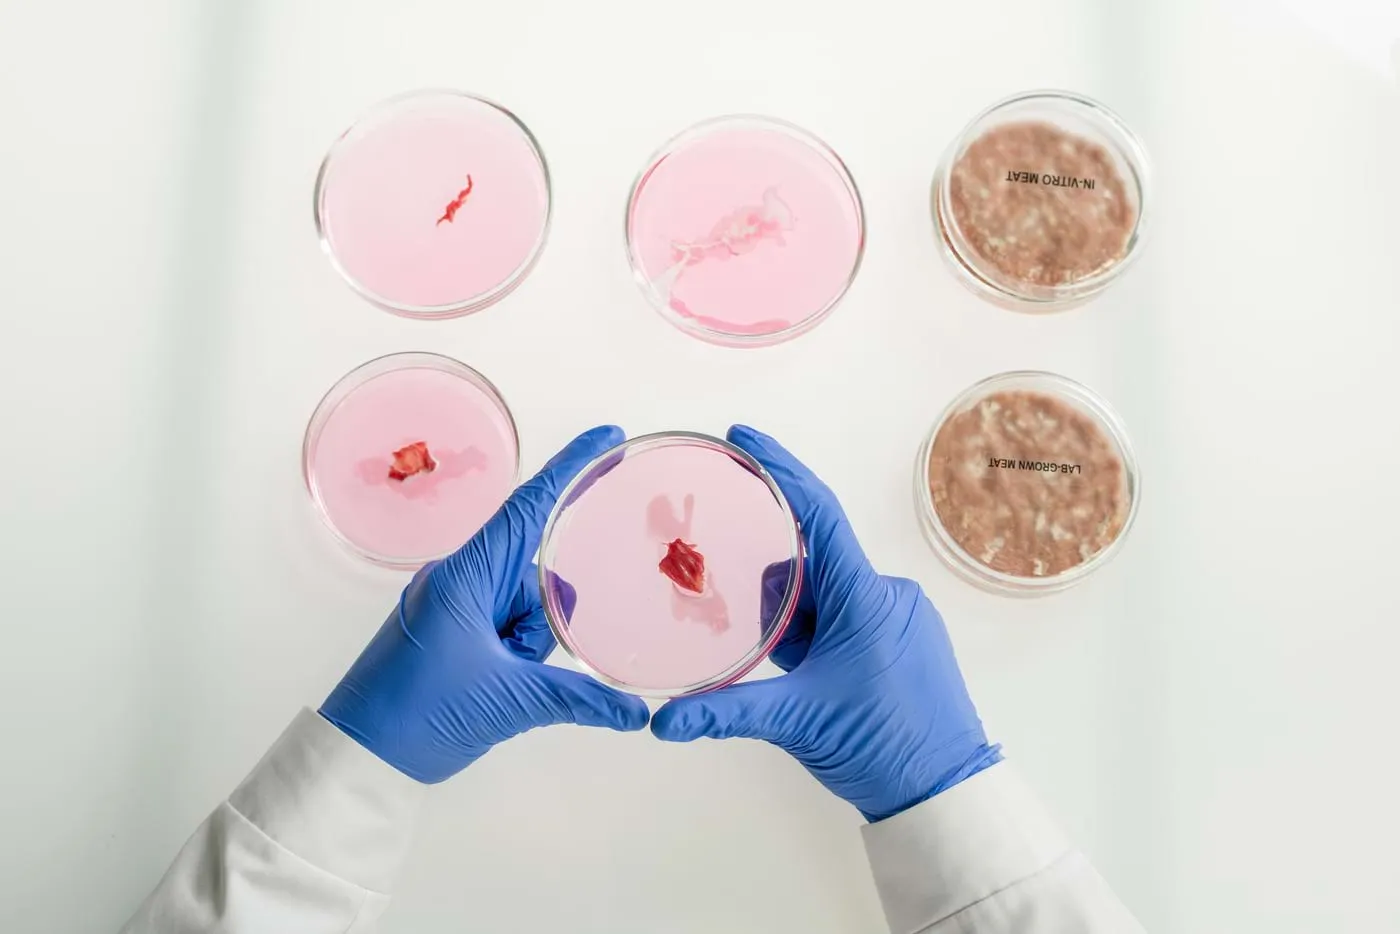

Jak groźna potrafi być salmonella? Kliknij po szczegóły!
Potrzebujesz recepty, zwolnienia lub konsultacji lekarskiej?
Zamów terazSalmonella – tajemnicza nazwa, która wywołuje odruch niepokoju, zwłaszcza u osób, które kiedykolwiek miały z nią styczność. Ta bakteria, choć niewielka i pozornie niegroźna, może sprawić, że nasze zdrowie zostanie poważnie zagrożone. Ale czym dokładnie jest salmonella, jak się przed nią chronić i co robić, gdy już nas zaatakuje? To pytania, na które warto znać odpowiedzi, zwłaszcza w czasach, gdy coraz częściej zwracamy uwagę na higienę, jakość spożywanych produktów i zdrowy tryb życia.
Skąd bierze się salmonella?
Salmonella to bakteria, która najczęściej przenoszona jest przez skażoną żywność lub wodę. Występuje głównie w surowym mięsie, jajach, mleku, ale także w owocach i warzywach, które miały kontakt z zakażonymi powierzchniami. Na pierwszy rzut oka wszystko może wyglądać na świeże i apetyczne, jednak brak odpowiednich procedur higienicznych w kuchni, brak mycia rąk lub niedostateczna obróbka termiczna jedzenia sprawiają, że salmonella bez problemu przenika do naszego organizmu.
Jednak nie tylko żywność jest źródłem zagrożenia. Salmonella może być również przenoszona przez zwierzęta – zwłaszcza ptaki i gady – oraz przez kontakt z zakażonymi osobami. Warto pamiętać, że choć często słyszymy o zakażeniach wywołanych surowym mięsem, to równie ważne jest odpowiednie mycie rąk po kontakcie ze zwierzętami, zwłaszcza jeśli mamy w domu egzotycznych pupili, jak żółwie czy jaszczurki.
Objawy zakażenia salmonellą
Pierwsze symptomy zakażenia mogą pojawić się już po kilku godzinach od spożycia skażonej żywności, choć czasem mogą minąć nawet dwa dni, zanim odczujemy pierwsze dolegliwości. Co ciekawe, nie u wszystkich objawy są takie same, a ich nasilenie zależy od wielu czynników, w tym wieku, stanu zdrowia i dawki bakterii, która trafiła do organizmu.
Najczęstszym objawem jest ostra biegunka, której towarzyszy ból brzucha, nudności oraz wymioty. Może pojawić się także gorączka, a w skrajnych przypadkach nawet dreszcze. Wraz z postępem choroby osoba zakażona może czuć się osłabiona, odwodniona, co w przypadku dzieci i osób starszych stanowi poważne zagrożenie. Choć objawy schorzenia mogą przypominać zwykłe zatrucie pokarmowe, nie wolno ich bagatelizować. Nieleczona infekcja może prowadzić do poważnych komplikacji, zwłaszcza jeśli bakterie przedostaną się do krwiobiegu, co nazywa się salmonellozą układową. W takiej sytuacji pacjent może wymagać hospitalizacji.
Czy salmonella jest groźna?
Z pozoru schorzenie może wydawać się jedynie nieprzyjemnym wspomnieniem po zjedzeniu niedogotowanego mięsa. Jednak jej potencjalne powikłania mogą być naprawdę groźne, szczególnie dla osób z obniżoną odpornością, małych dzieci, osób starszych oraz kobiet w ciąży. Jednym z najpoważniejszych powikłań salmonelli jest odwodnienie, które pojawia się na skutek biegunki i wymiotów. Kiedy organizm traci zbyt dużo płynów, może dojść do zaburzeń elektrolitowych, co w skrajnych przypadkach prowadzi do zagrażających życiu stanów, takich jak niewydolność nerek czy zaburzenia pracy serca.
Innym zagrożeniem jest ryzyko przedostania się bakterii do krwiobiegu, co może spowodować sepsę. Sepsa, zwana także posocznicą, to stan bezpośredniego zagrożenia życia, który wymaga natychmiastowej interwencji medycznej. U osób, u których dojdzie do salmonellozy układowej, mogą pojawić się również infekcje narządów wewnętrznych, takie jak zapalenie stawów, zapalenie kości czy zapalenie wsierdzia.
Jak zapobiegać zakażeniu salmonellą?
Zapobieganie zakażeniu to przede wszystkim kwestia odpowiedniej higieny i dbałości o to, co spożywamy. Pierwszym krokiem jest oczywiście staranne mycie rąk przed przygotowywaniem jedzenia, po kontakcie z surowym mięsem oraz po każdym wyjściu do toalety. W kuchni ważne jest też unikanie krzyżowego zanieczyszczenia. Surowe mięso, jajka i inne produkty, które mogą być źródłem bakterii, nie powinny mieć kontaktu z gotowymi potrawami.
Nie zapominajmy o myciu owoców i warzyw, nawet tych, które zamierzamy obrać. Warto również przestrzegać zasad odpowiedniej obróbki termicznej. Salmonella ginie w wysokich temperaturach, dlatego zawsze upewnijmy się, że nasze potrawy są dokładnie ugotowane lub upieczone. W przypadku jajek, które są jednym z głównych źródeł zakażenia, ważne jest, aby unikać jedzenia ich w surowej postaci. Majonezy domowej roboty, desery z surowymi jajkami, takie jak tiramisu, czy nawet klasyczne bezy mogą być ryzykowne, jeśli nie mamy pewności co do jakości jajek.
Co robić, gdy dojdzie do zakażenia?
W przypadku podejrzenia zakażenia salmonellą, szczególnie jeśli objawy są nasilone, najlepiej skontaktować się z lekarzem. Leczenie salmonelli zazwyczaj polega na łagodzeniu objawów, przede wszystkim nawodnieniu organizmu. W przypadku dzieci i osób starszych często konieczna jest hospitalizacja, zwłaszcza jeśli istnieje ryzyko odwodnienia.
Antybiotyków zazwyczaj nie praktykuje się w leczeniu salmonelli, chyba że mamy do czynienia z poważnymi powikłaniami. W większości przypadków organizm sam sobie poradzi z infekcją, choć proces ten może trwać od kilku dni do kilku tygodni. Ważne jest, aby w trakcie choroby pić dużo płynów – najlepiej wody lub specjalnych roztworów elektrolitowych. Unikajmy jednak napojów gazowanych, kawy czy herbaty, które mogą nasilać objawy.
Czy można przejść salmonellę bezobjawowo?
Odpowiedź brzmi: tak. U niektórych osób zakażenie salmonellą może przebiegać bezobjawowo, co oznacza, że nie odczuwają oni żadnych typowych dolegliwości, takich jak biegunka czy gorączka. Tacy nosiciele mogą jednak przenosić bakterie na innych, co stanowi dodatkowe zagrożenie w kontekście rozprzestrzeniania się choroby. Dlatego tak ważne jest dbanie o higienę, nawet jeśli nie odczuwamy żadnych objawów.
Salmonella, a podróże
Salmonella jest powszechna na całym świecie, ale ryzyko zakażenia może wzrosnąć podczas podróży, zwłaszcza do krajów o niższym standardzie higieny. W krajach tropikalnych czy rozwijających się warto zwrócić szczególną uwagę na jakość spożywanych posiłków oraz wody. W takich miejscach lepiej unikać surowych potraw, nieprzegotowanej wody oraz lodu, który mógł zostać zrobiony z wody niepewnego pochodzenia.
Podsumowanie
Salmonella, choć może wydawać się jedynie nieprzyjemnym incydentem, to w rzeczywistości poważne zagrożenie dla zdrowia. Ta bakteria, przenoszona głównie przez skażoną żywność, może prowadzić do poważnych powikłań, zwłaszcza u osób z obniżoną odpornością. Objawy, takie jak biegunka, wymioty, gorączka i ból brzucha, są wyraźnym sygnałem, że organizm zmaga się z zakażeniem. Dbanie o higienę, staranne mycie rąk oraz odpowiednie przygotowanie posiłków to najlepsze sposoby na uniknięcie zakażenia. Jeśli jednak dojdzie do infekcji, kluczem jest szybka reakcja – nawodnienie organizmu i, w razie potrzeby, konsultacja z lekarzem.